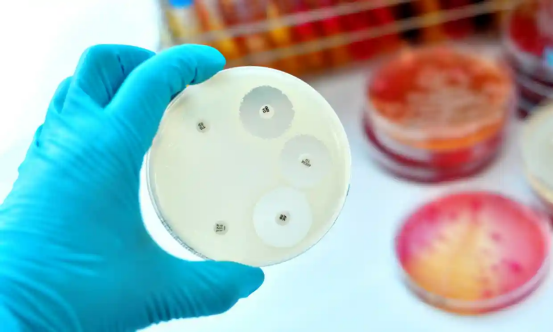
1739324175496160.png image.png

杨冰
阅读量:528
在全球抗菌药物耐药性日益严峻的背景下,新型抗生素的问世无疑为多重耐药菌感染的治疗带来了前所未有的曙光。这些创新药物不仅展示了强大的抗菌活性,还具备对多种耐药菌的抑制作用,为临床医生提供了更多治疗选择,也为患者带来了新的生存希望。

近年来,随着抗菌药物的广泛使用,多重耐药菌(MDR)感染已成为全球公共卫生领域的一大挑战。多重耐药菌是指对多种抗菌药物产生耐药性的细菌,它们能够逃避传统抗生素的杀伤作用,导致感染难以控制,治疗成功率低下,甚至引发死亡。据世界卫生组织(WHO)报告,多重耐药菌感染已成为全球死亡的主要原因之一,每年导致数百万人死亡。
因此,新型抗生素的研发对于控制多重耐药菌感染、保障人类健康具有重要意义。这些新型抗生素不仅有望填补现有治疗手段的空白,还可能通过其独特的抗菌机制,为多重耐药菌感染的治疗带来新的突破。
近年来,全球科研人员在新型抗生素的研发领域取得了显著进展,多种具有创新性和潜力的新型抗生素相继问世。
来法莫林(Lefamulin):
来法莫林是一种创新截短侧耳素类抗菌药物,于2019年获得美国食品药品监督管理局(FDA)批准上市。它通过抑制细菌核糖体的肽基转移酶中心(PTC),有效阻断细菌蛋白质的合成,从而发挥抗菌作用。
来法莫林对大环内酯类耐药微生物及耐甲氧西林金黄色葡萄球菌(MRSA)具有显著效果,且对社区获得性细菌性肺炎(CABP)的治疗表现出良好疗效。
康替唑胺(Contezolid):
康替唑胺是一种新一代噁唑烷酮类抗菌药物,其药代动力学参数优于利奈唑胺,对骨髓抑制的影响更小。
康替唑胺对MRSA和甲氧西林敏感金黄色葡萄球菌(MSSA)均表现出强大的抗菌活性,且在复杂性皮肤和软组织感染的治疗中显示出与利奈唑胺相当的有效性和安全性。
头孢比罗(Ceftobiprole):
头孢比罗是第五代原研头孢菌素,具有超广谱抗菌活性,对金黄色葡萄球菌(包括MRSA)、肺炎链球菌、流感嗜血杆菌等多种革兰阳性菌和革兰阴性菌均有效。
头孢比罗在治疗复杂性金黄色葡萄球菌菌血症方面表现出不劣于达托霉素的疗效。
奈诺沙星(Nemonoxacin):
奈诺沙星是新一代无氟喹诺酮类药物,具有广谱抗菌活性,特别是对耐青霉素肺炎链球菌(PRSP)和MRSA具有强大的抗菌作用。
奈诺沙星在国内已被列入国家医保目录,并在临床实践中广泛用于治疗多种感染性疾病。
美罗培南/韦博巴坦(Meropenem/Vaborbactam):
美罗培南/韦博巴坦是一种新型碳青霉烯类与β-内酰胺酶抑制剂的合剂,对产KPC的碳青霉烯耐药肠杆菌(CRE)等耐药菌具有显著疗效。
该药物在治疗CRE感染方面表现出高临床成功率,为CRE感染的治疗提供了新的选择。
依拉环素(Eravacycline):
依拉环素是全合成的四环素类衍生物,具有强效的抗菌活性和良好的组织渗透性。
依拉环素在治疗碳青霉烯耐药肺炎克雷伯菌(CRKP)等耐药菌引起的感染中表现出色,临床症状改善率高达95.5%。
头孢地尔(Cefiderocol):
头孢地尔是全球首个利用细菌自身的铁吸收系统进入细菌细胞的铁载体头孢菌素,对广谱需氧革兰阴性病原体具有广泛抗菌活性。
头孢地尔在治疗CRE引起的肾盂肾炎和复杂性尿路感染(cUTI)等方面表现出色,成为CRE感染治疗的重要选择。
新型抗生素的问世为多重耐药菌感染的治疗带来了新的希望,但在临床应用中仍面临诸多挑战。
临床应用经验不足:
由于新型抗生素上市时间较短,临床医生对其疗效、安全性和适应症等方面的了解尚不充分。因此,在临床应用中需要谨慎评估患者的具体情况,制定合理的治疗方案。
耐药性风险:
尽管新型抗生素对多重耐药菌具有强大的抗菌作用,但随着其广泛使用,细菌对其产生耐药性的风险也在增加。因此,需要加强对细菌耐药性的监测和研究,及时调整治疗方案。
药物可及性与成本:
新型抗生素的研发和生产成本较高,导致其市场价格昂贵。这在一定程度上限制了其在临床上的广泛应用。因此,需要探索降低药物成本、提高药物可及性的途径。
政策与法规支持:
为了推动新型抗生素的临床应用和发展,需要政府和相关机构出台相应的政策和法规支持。例如,加快新型抗生素的审批流程、纳入医保目录等措施,以降低患者负担并促进药物的普及使用。
随着科技的不断进步和全球科研人员的共同努力,新型抗生素的研发和应用将迎来更加广阔的发展前景。未来,我们可以期待以下几个方面的发展:
更多创新药物问世:
随着对细菌耐药机制的深入研究和新型药物筛选技术的不断进步,将有更多具有创新性和潜力的新型抗生素问世。这些药物将针对多重耐药菌的不同耐药机制发挥作用,为临床医生提供更多治疗选择。
精准医疗与个性化治疗:
随着精准医疗技术的不断发展,未来新型抗生素的应用将更加注重个体化差异和精准治疗。通过基因检测等手段了解患者的耐药基因型和感染菌株类型等信息,为患者制定更加个性化的治疗方案以提高治疗效果并降低耐药性风险。
跨学科合作与国际交流:
新型抗生素的研发和应用需要跨学科合作和国际交流的支持。未来我们将看到更多来自不同领域和国家的科研人员共同合作推动新型抗生素的发展和应用进程。
公众健康教育与意识提升:
提高公众对抗菌药物耐药性的认识和意识也是未来发展的重要方向之一。通过加强健康教育和宣传等手段提高公众对合理使用抗菌药物的重要性的认识并鼓励其积极参与抗菌药物耐药性的防控工作共同维护人类健康和安全。
新型抗生素的问世为多重耐药菌感染的治疗带来了新的曙光和希望。这些创新药物不仅展示了强大的抗菌活性还为临床医生提供了更多治疗选择。然而,在临床应用中仍需谨慎评估患者的具体情况并关注耐药性风险等问题。未来随着科技的不断进步和全球科研人员的共同努力我们有理由相信新型抗生素的研发和应用将迎来更加广阔的发展前景并为人类健康事业做出更大贡献。
寻找优质医疗资源  伴您走上康复之路